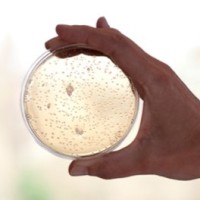
Lanthio Pharma

Company Details
- Employees
- 1
- Address
- Rozenburglaan 13 B, Groningen,groningen 9727 Dl,netherlands
- Phone
- 31 50 305 0240
- in****@****rma.com
- Industry
- Research Services
- NAICS
-
Scientific Research and Development ServicesResearch and Development in the Physical, Engineering, and Life SciencesResearch and Development in the Physical, Engineering, and Life Sciences (except Nanotechnology and Biotechnology)
- Website
- lanthiopharma.com
- Keywords
- peptides, lanthipeptides, GPCR, phage display, drug discovery, drug development, early development, oncology, critical care medicine, unmet medical need, stabilized peptides, receptor agonists.
- HQ
- Groningen, Groningen